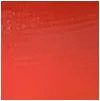
Skinny Lucite Hoop Earring- Pomegranate sold by Alexis Bittar product image thumbnail 5

Skinny Lucite Hoop Earring- Pomegranate
Product Description
Lightweight and artistic, these Lucite hoops showcase a hand-carved and hand-painted design with a vibrant color gradient. Made from 14k gold plated brass and surgical steel, they ensure durability and comfort. Measuring 2 inches in length and 0.25 inches in width, these hoops are perfect for both casual and elegant occasions. Crafted in Brooklyn, NY, they embody a unique blend of style and craftsmanship that elevates any outfit. From the brand: Details Lightweight classic Lucite hoops, hand-carved and hand-painted with precision. 14k gold plated brass, brass ear nut, surgical steel ear post, Lucite Our Lucite is hand-carved and hand-painted in Brooklyn, NY 2g, lightweight UPC: 889519136765 Measurements 2" length x .25" width Care To clean, gently wipe the surface with a soft cloth. For additional care instructions visit our FAQ page.











